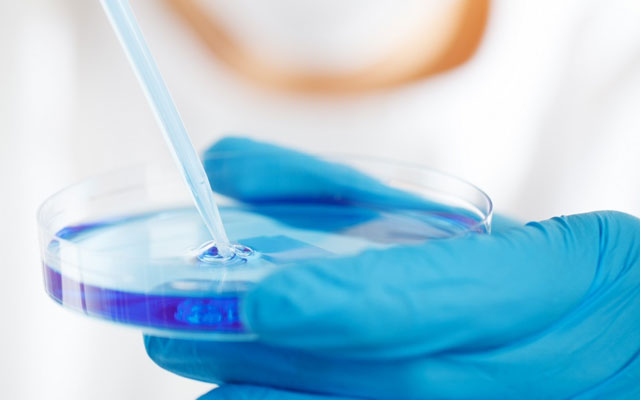
Auto tests Salles-la-Source

Commander des autotests à Salles-la-Source
COMMANDER
COMMANDER
Masques gratuits distribués, bénéfices reversés
 NOS ACTIONS
NOS ACTIONS



Masques FFP2, protections virus
Commandez des autotests covid-19 pas chers, livraison Salles-la-Source 48h
Coronavirus Covid-19, autotest
Recherches courantes autotests autour de Salles-la-Source
14/02/2026 - Vente test Salles-la-Source
20/02/2026 - Livraison autotests Salles-la-Source
20/02/2026 - Livraison test Salles-la-Source contre coronavirus
19/02/2026 - Achat test Salles-la-Source
09/02/2026 - Trouver autotests Salles-la-Source contre coronavirus
10/02/2026 - Rechercher autotests 12330 Salles-la-Source
03/02/2026 - Commander autotests Salles-la-Source
14/02/2026 - Rechercher autotests Salles-la-Source
28/02/2026 - Commander test Salles-la-Source en ligne dépistage covid
26/02/2026 - Commander autotests Salles-la-Source en stock
04/02/2026 - Vente autotests Salles-la-Source
04/02/2026 - Rechercher test Salles-la-Source contre virus
09/02/2026 - Achat test Salles-la-Source contre covid 19
02/02/2026 - Achat autotest Salles-la-Source contre covid 19
28/02/2026 - Achat test à Salles-la-Source en stock
16/02/2026 - Trouver auto-test Salles-la-Source
13/02/2026 - Acheter autotest Salles-la-Source
12/02/2026 - Achat test Salles-la-Source Covid variant Delta
26/02/2026 - Achat auto-test Salles-la-Source dépistage
05/02/2026 - Trouver test Salles-la-Source contre coronavirus
20/02/2026 - Livraison test Salles-la-Source covid 19
06/02/2026 - Vente autotests Salles-la-Source rapide dépistage covid
25/02/2026 - Commander autotest Allemand Salles-la-Source
20/02/2026 - Vente autotests à Salles-la-Source
06/02/2026 - Rechercher autotest Salles-la-Source rapide
09/02/2026 - Acheter autotests Salles-la-Source en stock
28/02/2026 - Acheter autotest à Salles-la-Source covid 19
04/02/2026 - Rechercher test Salles-la-Source
16/02/2026 - Trouver autotests Salles-la-Source
09/02/2026 - Commander autotests Salles-la-Source dépistage covid
14/02/2026 - Rechercher autotest Salles-la-Source dépistage covid
24/02/2026 - Acheter test Salles-la-Source en ligne Covid variant Delta
24/02/2026 - Commande autotests 12330 Salles-la-Source en ligne virus
09/02/2026 - Trouver autotests à Salles-la-Source
01/02/2026 - Acheter test Salles-la-Source en stock dépistage
24/02/2026 - Recherche autotests à Salles-la-Source rapide
07/02/2026 - Livraison autotest Salles-la-Source covid 19
26/02/2026 - Vente auto-test Salles-la-Source rapide dépistage
02/02/2026 - Rechercher autotest Salles-la-Source
09/02/2026 - Rechercher autotests Salles-la-Source en ligne
28/02/2026 - Achat autotests Salles-la-Source
08/02/2026 - Acheter autotests Salles-la-Source dépistage covid
11/02/2026 - Rechercher test Salles-la-Source
12/02/2026 - Acheter autotests Salles-la-Source
15/02/2026 - Acheter test Salles-la-Source
16/02/2026 - Commande autotests 12330 Salles-la-Source
25/02/2026 - Livraison autotest à Salles-la-Source
02/02/2026 - Vente autotests Salles-la-Source dépistage
11/02/2026 - Commander autotest Allemand Salles-la-Source covid 19
18/02/2026 - Livraison test Salles-la-Source
24/02/2026 - Commander autotests Salles-la-Source en stock dépistage covid
21/02/2026 - Rechercher autotest Salles-la-Source en stock dépistage
13/02/2026 - Vente autotest Salles-la-Source virus
18/02/2026 - Commander autotest Salles-la-Source
18/02/2026 - Recherche autotests Salles-la-Source covid 19
27/02/2026 - Livraison auto-test Salles-la-Source contre coronavirus
13/02/2026 - Vente autotests Salles-la-Source
25/02/2026 - Livraison test 12330 Salles-la-Source contre covid 19
05/02/2026 - Commande autotests 12330 Salles-la-Source en ligne Covid variant Delta
19/02/2026 - Rechercher autotests à Salles-la-Source en ligne contre covid 19
07/02/2026 - Commander test 12330 Salles-la-Source
16/02/2026 - Recherche autotest Allemand Salles-la-Source dépistage covid
09/02/2026 - Livraison auto-test Salles-la-Source coronavirus
15/02/2026 - Vente autotest Salles-la-Source en ligne Covid variant Delta
01/02/2026 - Vente autotest Salles-la-Source dépistage
04/02/2026 - Acheter autotest Salles-la-Source virus
18/02/2026 - Commande autotest Salles-la-Source en ligne
06/02/2026 - Commander autotests Salles-la-Source rapide
24/02/2026 - Achat autotests Salles-la-Source
01/02/2026 - Commander auto-test Salles-la-Source
11/02/2026 - Trouver autotest Allemand Salles-la-Source dépistage covid
26/02/2026 - Vente autotest Allemand Salles-la-Source dépistage covid
05/02/2026 - Rechercher autotests Salles-la-Source
11/02/2026 - Commander auto-test Salles-la-Source rapide
16/02/2026 - Achat autotest Salles-la-Source en ligne
12/02/2026 - Vente autotest à Salles-la-Source
21/02/2026 - Achat autotests Salles-la-Source en stock Covid variant Delta
05/02/2026 - Trouver test Salles-la-Source dépistage
07/02/2026 - Commande autotest Salles-la-Source rapide
16/02/2026 - Livraison autotests Salles-la-Source
03/02/2026 - Vente autotest Salles-la-Source contre virus
06/02/2026 - Acheter autotest Allemand Salles-la-Source en stock
18/02/2026 - Livraison test Salles-la-Source rapide coronavirus
10/02/2026 - Commander autotest Salles-la-Source rapide
15/02/2026 - Commande autotest Allemand Salles-la-Source
03/02/2026 - Acheter autotest Allemand Salles-la-Source en ligne
15/02/2026 - Trouver autotests Salles-la-Source
19/02/2026 - Livraison test Salles-la-Source



Masques FFP2, protections virus
Commandez des masques FFP2 pas chers, livraison Salles-la-Source 48h



Masques FFP2, protections virus
Commandez des masques FFP2 pas chers, livraison Salles-la-Source 48h
Coronavirus Covid-19, trouver des protections
Acheter des masques FFP2 dans une pharmacie à Salles-la-Source ou proche de Salles-la-Source
Biohazard Protection soutient les commerces de proximité à Salles-la-Source ou proche de Salles-la-Source : pour vous protéger du virus et du variant Delta, vos devez être vacciné, détenir un pass sanitaire, et/ou vous devez acheter des équipements de protection individuels comme des masques FFP2 français (Made in France) ou chirurgicaux / médicaux (Pas des masques en tissu car ils seront prochainement interdits dans certains lieux) ou du gel, ou encore des autotests dans vos commerces de proximité proche de chez vous à Salles-la-Source comme les pharmacies, protections, les petits commerçants locaux de Salles-la-Source ou proches, les magasins de vêtements et autres ; ou les hypermarchés comme Leclerc, Carrefour, Cora, Hyper U, Auchan, Géant Casino, Intermarché ou les grandes surfaces de Salles-la-Source ou autour de Salles-la-Source, supermarchés comme Carrefour Market, Super U, Monoprix, Lidl, Aldi, Franprix, Leader Price, Netto, Action, Gifi, etc, à Salles-la-Source ou pas loin. Il est également possible de trouver des masques dans des magasins comme leroy Merlin, Castorama, Bricorama, Bricomarché ou encore Mr Bricolage à Salles-la-Source ou à côté. Bien sûr il est possible de s'en procurer en ligne sur les sites Internet de ces enseignes françaises avec une livraison à Salles-la-Source, ou encore des sites comme Amazon voir E-bay.
Enfin, vous pouvez évidemment commander des masques sur notre site biohazard-protection.fr avec une Livraison de masques, autotests en 48h à Salles-la-Source, de coronavirus covid-19 en complément du pass sanitaire et de la vaccination.
Pharmacie Philoreau Redon (SNC)
9 av Joseph Vidal 12330 VILLECOMTAL | Téléphone : 05 65 44 60 04
Achat masques, gants, autotests, gel hydroalcolique sur place ou sur commande..
Pharmacie Monestier
26 tour Ville 12330 MARCILLAC VALLON | Téléphone : 05 65 71 72 03
Achat autotests, gants, masques, gel hydroalcolique sur commande ou sur place..
Pharmacie Cammas Vigier
1 rte Decazeville 12330 SAINT CHRISTOPHE VALLON | Téléphone : 05 65 72 68 11
Achat autotests, gants, masques, gel hydroalcolique sur place ou sur commande..
Biohazard Protection™, une référence nationale
Ils font confiance aux équipements EPI Biohazard Protection™
Entreprises de Salles-la-Source, associations de Salles-la-Source, institutions de Salles-la-Source comme la Mairie, utilisent ou non les EPI distribués par Biohazard Protection™
Courant mars 2020 deux professionnels biens connus du milieu du voyage français créent l'association EFC avec l'objectif de distribuer gratuitement un million de masques aux hôpitaux, soignants et EHPAD. Depuis la mi-avril 2020 et pendant les confinements, les deux entrepreneurs ont élargi leur gamme en créant Biohazard Protection™ et aident désormais les collectivités locales, professions libérales et entreprises à se protéger contre le nouveau Coronavirus (SARS-CoV-2), COVID-19. Biohazard Protection™ reverse 3% de ses bénéfices à l'association.



